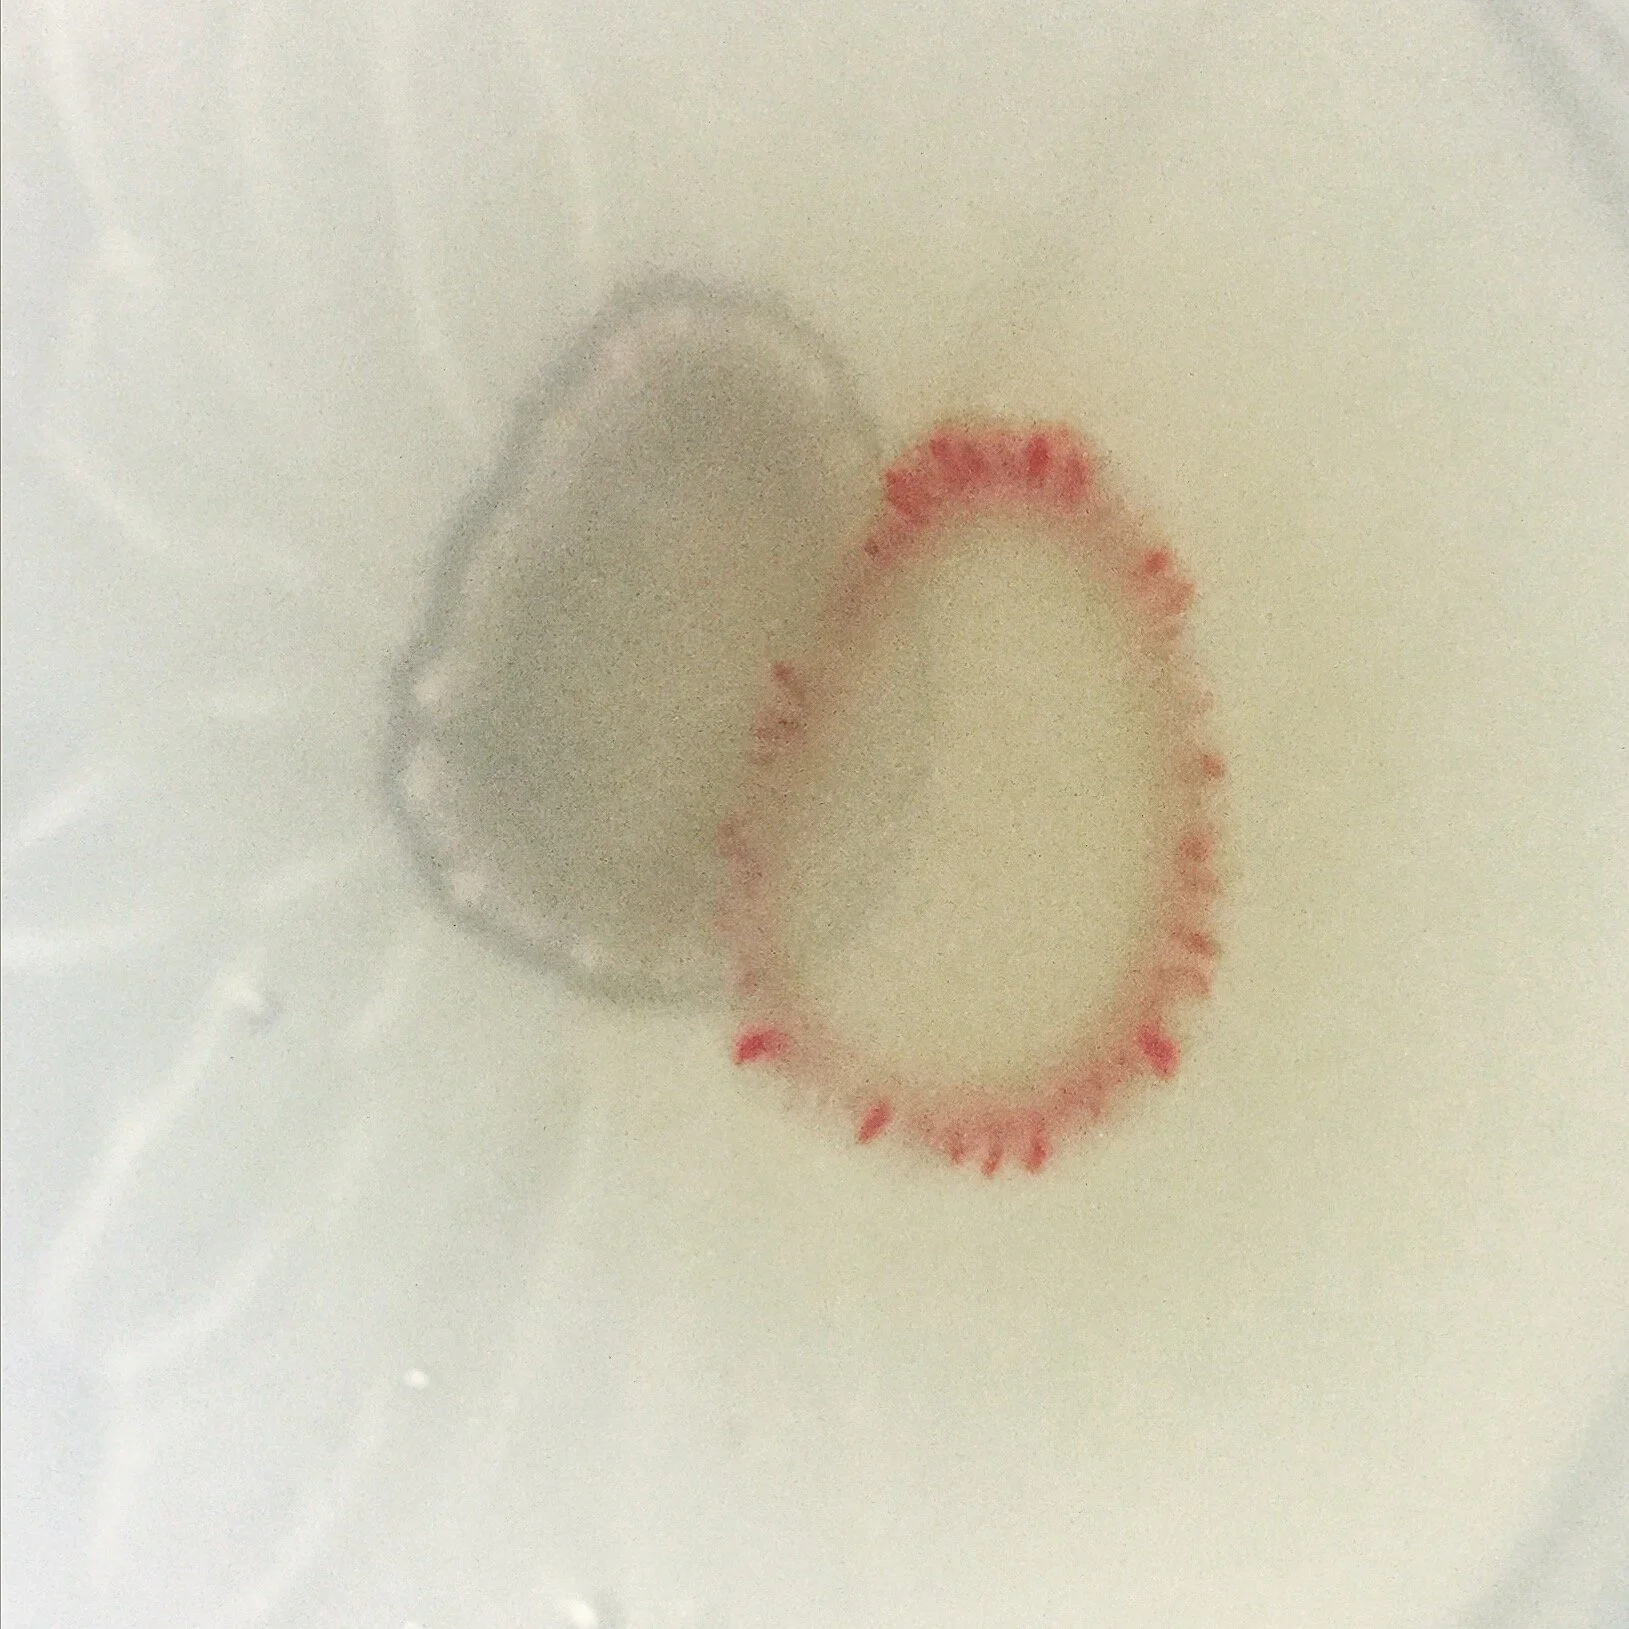
serratia1_iphone.JPG

I enjoy photography, and particularly, micrography and video microscopy. During graduate school, I have rebuilt several light microscopes, ranging from a standard inverted epifluorescent machines (eg. Olympus IX51), to a beautiful old Zeiss Ultraphot II given by one of my thesis advisors.
Image Credit: Zeiss Ultraphot II Manual

I have also studied image processing methods, including deconvolution, focus stacking, and editing using a combination of ImageJ/Fiji and Adobe CC. Shown here is a strew of radiolaria.
Image Credit: Sunanda Sharma

I use a combination of cameras in this work, ranging from CMOS and CCD types, as well as DSLRs, iPhones, scanners, and digital microscopes. Shown here are diatoms (Pyrocystis fusiformis) viewed with a Wild Makroskop M420.
Image Credit: Sunanda Sharma

I am currently learning to improve my methods through reading books by Shinya Inoué, Felice Frankel, and others.
Image Credit: Sunanda Sharma

Oxidation reaction products dried upon a slide and subsequently imaged.
Image Credit: Sunanda Sharma

Bacillus subtilis grown on soft agar can form unique patterns sometimes known as Van Gogh Swirls. Fluorescence micrograph, 63x.
Image Credit: Sunanda Sharma

Fluorescence micrograph of GFP and RFP producing engineered Escherichia coli.
Image Credit: Sunanda Sharma, Rachel Soo Hoo Smith, Tzu Chieh Tang

Colonies of Escherichia coli bacteria engineered to inducibly produce an enzyme capable of cleaving a synthetic substrate, yielding an indigo-like color. Optical micrograph, 40x, Zeiss Axioplan 2.
Image Credit: Sunanda Sharma, Rachel Soo Hoo Smith

Butterfly wings are made up of chitinous scales, arranged to form structure and color patterns. This is an optical micrograph of the wing of a monarch butterfly (Danaus plexippus).
Image Credit: Sunanda Sharma

Close up SEM micrograph of the wing scale of the Morpho butterfly, known for its striking blue color formed from structure rather than pigment.
Image Credit: Sunanda Sharma

A focus-stacked composite image of a wildflower sample from Cederberg, Western Cape, collected in September 2018.
Image Credit: Sunanda Sharma

A scanning electron micrograph of the interior of a silk cocoon spun by the domesticated silkworm, Bombyx mori.
Image Credit: Sunanda Sharma

Each silkworm spins layer upon layer of fiber, held together by sericin, to create a protective cocoon in which they metamorphosize from larva to adult moth.
Image Credit: Sunanda Sharma

Hyphae of the fungus Aspergillus niger. Optical micrograph taken at 10x.
Image Credit: Sunanda Sharma

Sporangium of the fungus Aspergillus niger. Their black color is provided by the pigment melanin.
Image Credit: Sunanda Sharma and Nic Lee

Aspergillus niger and other related, highly melanized species have been found in high radiation and extreme environments, such as the interior of the International Space Station.
Image Credit: Sunanda Sharma and Nic Lee